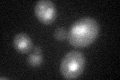
YDL102W

View description
Catalytic subunit of DNA polymerase delta; required for chromosomal DNA replication during mitosis and meiosis, intragenic recombination, repair of double strand DNA breaks, and DNA replication during nucleotide excision repair (NER)
Localization:
Intensity:
Fold change:
Significance:
-
C’ GFP library in SD

nucleus25.25 -
N' NOP1pr-GFP in SD

nucleus107.363 -
N' TEF2pr-mCherry in SD

nucleus33.6948 -
N' NATIVEpr-GFP in SD

nucleus30.4638 -
N' TEF2pr-VC and Cyto-VN in SD

nucleus38.31 -
C’ GFP library in SD+DTT
nucleus17.130.67Yes -
C’ GFP library in SD+H2O2

nucleus27.081.07No -
C’ GFP library in Starvation Media

nucleus23.380.92No -
C’ GFP library on the background of Pup2-DaMP

nucleus -
C’ GFP library on the background of CCT mutant

nucleus22.45980.889382No
